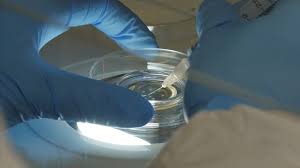
The Top-rated Healthcare Facilities in KSA for Medical Tourists

Healthcare tourism is a growing trend in the Kingdom of Saudi Arabia (KSA), with an increasing number of individuals from around the world seeking medical treatment in the country. In this paper, we will explore the phenomenon of healthcare tourism in KSA, examining the reviews and recommendations of patients who have sought medical care in the country. As the popularity of healthcare tourism continues to rise, it is important to understand the experiences and perspectives of those who have participated in this global healthcare trend. By analyzing reviews and recommendations, we aim to provide insights into the quality of healthcare services in KSA and offer valuable information for individuals considering medical treatment in the country.
Exploring Healthcare Tourism in KSA: Reviews and Recommendations is a comprehensive guide that outlines the various healthcare services available in Saudi Arabia for international visitors. The guide covers a wide range of medical specialties, hospitals, clinics, and healthcare providers, as well as reviews and recommendations from previous patients. It provides valuable insights and information for individuals seeking healthcare treatment in Saudi Arabia, including patient experiences, facility amenities, and overall satisfaction with the quality of care. Whether for elective procedures, specialized treatments, or general medical services, this guide offers a thorough resource for those considering healthcare tourism in KSA.
Exploring the Benefits of Healthcare Tourism in KSA
reviews of medical coordinators Saudi Arabia

Healthcare tourism in KSA has gained significant attention in recent years, with more and more individuals seeking medical treatment in the country. Reviews of healthcare facilities in KSA are overwhelmingly positive, with patients citing state-of-the-art technology, world-renowned medical professionals, and top-notch amenities as reasons for choosing KSA for their medical needs. With a focus on providing high-quality care and a range of specialized treatments, KSA has become a top destination for healthcare tourism.
Healthcare tourism in KSA (Kingdom of Saudi Arabia) offers numerous benefits for both patients and the country's healthcare industry. Patients from around the world come to KSA for medical treatment due to the high-quality healthcare services, advanced medical facilities, and affordable treatment costs. This trend not only boosts the country's healthcare sector but also contributes significantly to its economy. KSA's strategic location in the Middle East makes it easily accessible for patients from neighboring countries and beyond. Additionally, the country has been investing heavily in modernizing its healthcare infrastructure and adopting the latest technologies, further enhancing its appeal to medical tourists. Moreover, healthcare tourism in KSA has the potential to create job opportunities and drive the growth of related sectors such as hospitality, travel, and pharmaceuticals. By attracting international patients, the country can showcase its expertise in specialized medical treatments and procedures, positioning itself as a global hub for healthcare excellence. Overall, exploring the benefits of healthcare tourism in KSA reveals its potential to not only provide top-notch medical care to patients from around the world but also to positively impact the country's economy and healthcare industry.
The Top-rated Healthcare Facilities in KSA for Medical Tourists
luxury medical tourism ksa
The top-rated healthcare facilities in KSA for medical tourists include King Faisal Specialist Hospital & Research Centre in Riyadh, the Saudi German Hospital in Jeddah, and the Johns Hopkins Aramco Healthcare in Dhahran. These facilities offer a wide range of medical services and treatments, with state-of-the-art equipment and highly trained medical staff. They are known for providing excellent care and a comfortable experience for international patients seeking medical treatment in Saudi Arabia.
Why Healthcare Tourists Flock to KSA for Treatment

Healthcare tourists flock to KSA for treatment due to its high-quality medical facilities, skilled healthcare professionals, and advanced medical technology. The country has become a popular destination for medical tourism, offering a wide range of specialized treatments such as cardiac surgery, oncology, organ transplants, and cosmetic procedures. Additionally, the competitive pricing and luxury hospital accommodations make KSA an attractive option for patients seeking medical care abroad.
A Comparative Review of Healthcare Tourism in KSA
A Comparative Review of Healthcare Tourism in KSA is a comprehensive study that examines the current state of healthcare tourism in the Kingdom of Saudi Arabia (KSA) and compares it with other global healthcare tourism destinations. The review explores various factors such as the quality of healthcare services, infrastructure, regulatory framework, and cultural considerations to assess the competitiveness of KSA in attracting international patients for medical treatment. The study provides valuable insights for policymakers, industry stakeholders, and healthcare providers to enhance the healthcare tourism sector in KSA and position it as a leading destination for international patients seeking high-quality medical care.